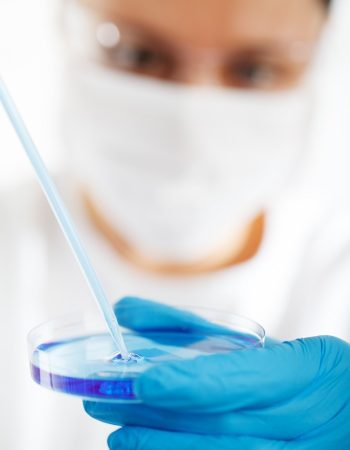

Services
Integrated Testing Solutions
Water Test
- Physical parameters,
- Chemical parameters,
- Microbiology tests,
- BOD,
- COD
Water and Food Quality Analysis
Water Quality Analysis focuses on evaluating physical, chemical, and microbiological parameters such as pH, turbidity, hardness, biological oxygen demand (BOD), and chemical oxygen demand (COD). It ensures that water is safe for consumption, industrial use, and environmental sustainability.
Food Quality Analysis examines the nutritional content, contamination, and safety of food products. This includes testing for microbial presence, chemical residues, and adherence to food safety standards to ensure that the food consumed is both safe and nutritious.

Water and food quality analysis play a crucial role in ensuring the health, safety, and well-being of individuals and communities. These analyses involve systematic testing of various parameters to assess the purity, safety, and compliance with regulatory standards.
Food Lab

- Milk,
- Spices,
- Oil,
- Tea powder.( Quality tests)
Education /Training

Internship
An internshipprovides valuable hands-on experience. These opportunities are ideal for students seeking practical exposure to enhance their knowledge and skills.

Projects
We offers diverse opportunities for academic projects that explore the fascinating world of microorganisms. Here are some innovative and practical project ideas….

Training
Industrial training in food technology offers students and professionals hands-on exposure to the practical aspects of food production, quality assurance, and research.